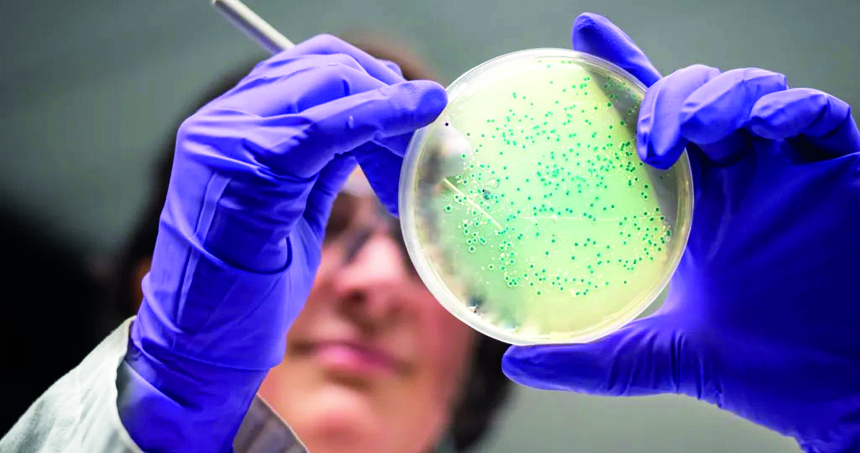
এআই উদ্ভাবিত অ্যান্টিবায়োটিক ধ্বংস করলো গনোরিয়ার ‘সুপারবাগ’

ওষুধ প্রতিরোধী গনোরিয়া ও এমআরএসএ (মেথিসিলিন-প্রতিরোধী স্ট্যাফিলোকক্কাস অরিয়াস) মোকাবিলায় দুটি নতুন অ্যান্টিবায়োটিক উদ্ভাবন করেছে কৃত্রিম বুদ্ধিমত্তা (এআই)। ম্যাসাচুসেটস ইনস্টিটিউট অব টেকনোলজির (এমআইটি) গবেষকরা জানিয়েছেন, এই ওষুধগুলোর ‘পরমাণু থেকে পরমাণু’ সম্পূর্ণভাবে এআই দিয়ে নকশা করা হয়েছে এবং ল্যাবরেটরি ও প্রাণীর ওপর পরীক্ষায় সুপারবাগ ধ্বংস করতে সক্ষম হয়েছে।
তবে বিশেষজ্ঞরা বলছেন, এই অ্যান্টিবায়োটিকগুলো বাজারে আসতে এখনো কয়েক বছরের কাজ বাকি। পরিমার্জন, নিরাপত্তা যাচাই ও দীর্ঘমেয়াদি ক্লিনিক্যাল ট্রায়ালের পরই এগুলো রোগীর জন্য ব্যবহৃত হতে পারবে। অ্যান্টিবায়োটিকের অতিরিক্ত ও ভুল ব্যবহার বিশ্বব্যাপী ব্যাকটেরিয়াকে আরও শক্তিশালী ও প্রতিরোধী করে তুলছে। বর্তমানে প্রতিবছর এ ধরনের সংক্রমণে ১০ লাখের বেশি মানুষের মৃত্যু হচ্ছে। কয়েক দশক ধরে নতুন অ্যান্টিবায়োটিকের অভাব এ সংকটকে আরও গভীর করেছে।
বৃহস্পতিবার (১৪ আগস্ট) রাতে বিবিসি জানিয়েছে, এর আগে এআই ব্যবহার করে বিদ্যমান রাসায়নিক যৌগের বিশাল ডেটাবেস থেকে সম্ভাব্য অ্যান্টিবায়োটিক খোঁজার চেষ্টা হয়েছে। কিন্তু এবার এমআইটির বিশেষজ্ঞেরা সরাসরি নতুন অণু ডিজাইন করতে এআই ব্যবহার করেছেন। বিশেষ করে, যৌনবাহিত রোগ গনোরিয়া ও প্রাণঘাতী এমআরএসএ ব্যাকটেরিয়ার বিরুদ্ধে কার্যকর অ্যান্টিবায়োটিক তৈরি করেছে।
এআই পরিচালিত ওই গবেষণায় ৩ কোটি ৬০ লাখ যৌগ বিশ্লেষণ করা হয়েছে। এমনকি এসব যৌগের অনেকগুলো বাস্তবে বিদ্যমান নয় বা এখনো আবিষ্কৃত হয়নি। গবেষকেরা এআইকে বিদ্যমান যৌগের রাসায়নিক গঠন ও তাদের বিভিন্ন ব্যাকটেরিয়ার ওপর প্রভাবের তথ্য দিয়ে প্রশিক্ষণ দেন। এরপর এআই শিখে নেয় কোন ধরনের আণবিক গঠন ব্যাকটেরিয়ার বৃদ্ধি বাধাগ্রস্ত করতে পারে। দুটি পদ্ধতিতে নতুন অ্যান্টিবায়োটিকের ডিজাইন করা হয়েছে। এ ক্ষেত্রে বিদ্যমান অ্যান্টিবায়োটিকের সঙ্গে খুব বেশি মিল রয়েছে কিংবা মানুষের জন্য বিষাক্ত হওয়ার সম্ভাবনা রয়েছে—এমন নকশাগুলো বাতিল করা হয়। উৎপাদনের পর ল্যাবে ও সংক্রমিত ইঁদুরের ওপর পরীক্ষায় দুটি নতুন যৌগ খুব ভালো ফল দেখিয়েছে।
এমআইটির অধ্যাপক জেমস কলিন্স বলেন, আমরা দেখাতে পেরেছি, জেনারেটিভ এআই সম্পূর্ণ নতুন অ্যান্টিবায়োটিক তৈরি করতে পারে। এতে সময় বাঁচে ও খরচ কমে এবং সুপারবাগের বিরুদ্ধে আমাদের অস্ত্রভান্ডার সমৃদ্ধ হয়।
তবে বিশেষজ্ঞরা সতর্ক করছেন, নিরাপত্তা ও কার্যকারিতা যাচাইয়ের দীর্ঘ ও ব্যয়বহুল প্রক্রিয়া এখনো বাকি রয়েছে। ইম্পিরিয়াল কলেজ লন্ডনের ড. অ্যান্ড্রু এডওয়ার্ডস বলেন, এটি একটি গুরুত্বপূর্ণ অগ্রগতি হলেও মানুষের ওপর ব্যবহারের আগে প্রচুর গবেষণা প্রয়োজন। আরও একটি বড় চ্যালেঞ্জ হলো উৎপাদনপ্রক্রিয়া। উদাহরণস্বরূপ, গনোরিয়ার জন্য ডিজাইন করা ৮০টি যৌগের মধ্যে মাত্র দুটি তৈরি করা সম্ভব হয়েছে। পাশাপাশি নতুন অ্যান্টিবায়োটিকের বাণিজ্যিক লাভ কম থাকায় ওষুধ কোম্পানিগুলো প্রায়ই এ ধরনের বিনিয়োগে আগ্রহ দেখায় না। কারণ, কার্যকারিতা বজায় রাখতে এ ধরনের ওষুধ সীমিতভাবে ব্যবহার করাই শ্রেয়। এ গবেষণা প্রমাণ করছে—এআই ভবিষ্যতে অ্যান্টিবায়োটিক আবিষ্কারে নতুন যুগের সূচনা করতে পারে।